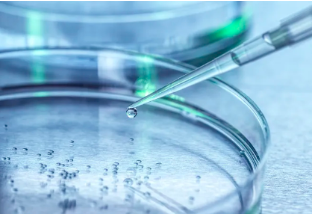
image.png

幹細胞免疫細胞制備過程複雜嗎?具體有哪些流程?
2024-11-01 14:22:54 來源: 小編 咨詢醫生
幹細胞和免疫細胞的制備是現**物醫學領域中的重要研究内容,對于治療多種疾病具有重要的應用價值。下面将詳細介紹幹細胞和免疫細胞的制備過程,并解答這一過程是否複雜。
首先,我們來看幹細胞制備的過程。幹細胞是一種具有自我更新能力和多向分化潛能的細胞,主要包括胚胎幹細胞和成體幹細胞。幹細胞的制備過程主要包括以下幾個步驟:
1.來源獲取:幹細胞的來源有胚胎、臍帶血、骨髓、脂肪組織等。根據不同的來源,獲取幹細胞的方法也會有所不同。
2.分離純化:獲取的原始組織中含有多種類型的細胞,需要通過特定的方法将幹細胞分離出來。常用的方法有密度梯度離心、免疫磁珠分選等。
3.培養擴增:分離得到的幹細胞在體外培養條件下進行擴增,以滿足臨床應用的需要。這一過程中,需要提供适宜的營養條件、生長因子和細胞因子等。
4.鑒定與篩選:對擴增的幹細胞進行生物學特性鑒定,确保其具有正常的生物學功能。此外,還需要對幹細胞進行篩選,去除可能存在的雜質和異常細胞。
接下來,我們來看免疫細胞制備的過程。免疫細胞主要包括T細胞、B細胞、巨噬細胞等,制備過程如下:
1.來源獲取:免疫細胞的來源主要是外周血、骨髓和臍帶血等。通過采集血液或提取骨髓,獲取免疫細胞。
2.分離純化:采用密度梯度離心、免疫磁珠分選等方法,将免疫細胞從原始組織中分離出來。
3.激活與擴增:在體外培養條件下,通過添加特定的激活劑和生長因子,促使免疫細胞活化并擴增。
4.鑒定與篩選:對擴增的免疫細胞進行生物學特性鑒定,确保其具有正常的生物學功能。
從以上流程可以看出,幹細胞和免疫細胞的制備過程具有一定的複雜性。具體體現在以下幾個方面:
1.來源多樣:幹細胞和免疫細胞的來源較多,需要針對不同來源采取不同的獲取方法。
2.純化與鑒定:制備過程中需要對細胞進行分離純化和生物學特性鑒定,确保細胞的純度和功能。
3.培養條件要求高:幹細胞和免疫細胞在體外培養過程中對營養條件、生長因子和細胞因子等要求較高,需要嚴格控制培養條件。
4.安全性問題:在制備過程中,要嚴格防止細菌、病毒等污染,确保制備的細胞安全有效。
總之,幹細胞和免疫細胞的制備過程确實具有一定的複雜性。但随着生物技術的不斷發展,我國在這一領域已取得顯著成果,制備過程正在逐漸優化。相信在不久的将來,這一技術将爲更多患者帶來福音。
-
上一頁: 幹細胞到血細胞過程是怎樣的?需要多久?
- 2024-10-15提取幹細胞的過程是什麽,詳解幹細胞提取方法步驟
- 2024-11-12甘肅誘導幹細胞有何作用,臨床應用前景如何
- 2024-11-10煙台幹細胞研究中心怎麽樣,靠譜嗎
- 2024-11-06幹細胞增殖過程中,是否需要進行DNA複制?
- 2024-10-21蘋果幹細胞功效有哪些案例?
- 2024-10-24幹細胞外泌體注射安全嗎,外泌體注射的功效作用及注意事項
- 2024-08-12幹細胞注射适合什麽年齡的人群
- 2024-10-11牙髓幹細胞研究進展如何?臨床應用效果怎樣?
- 2024-09-13山東莒縣捐贈幹細胞機構有哪些,内附名單表
- 2024-09-01廣州幹細胞存儲多少錢一年,不同類型細胞存儲費用
- 2024-08-26造血幹細胞是骨髓嗎,造血幹細胞與骨髓區别
- 2024-07-19幹細胞是什麽東西,幹細胞從哪裏提取出來
- 2024-08-03幹細胞治療慢阻肺,幹細胞治療慢阻肺效果怎麽樣
- 2024-08-05美國幹細胞技術,美國幹細胞技術怎麽樣
- 2024-10-04幹細胞與免疫細胞作用揭秘,它們如何協同工作
- 2024-10-02骨髓幹細胞移植要多少錢,費用因素有哪些考慮
- 2024-10-07幹細胞技術與種類繁多,如何選擇适合自己的幹細胞?
- 2024-09-18用幹細胞抗衰老治療好嗎,續效果怎麽樣
